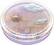
Alt View 4. PopSockets - PopTop Swappable Universal Grip for Cell Phones, TOP ONLY, Compatible with Any PopGrip Base - Dreamy Whirl.

Questions & Answers
Page Showing 1-7 of 7 questions
Q: QuestionDoes this grip provide a secure hold?
- A:Answer Yes, this grip provides a strong hold for one-handed use.
This question and answer was generated by AI based on customer and product data.Q: QuestionWhat is the warranty on labor for this item?
- A:Answer The warranty on labor for this item is 3 years.
This question and answer was generated by AI based on customer and product data.Q: QuestionIs this grip compatible with any phone?
- A:Answer Yes, this is a universal grip compatible with cell phones.
This question and answer was generated by AI based on customer and product data.Q: QuestionDoes this grip work as a stand?
- A:Answer Yes, this grip can work as a horizontal stand.
This question and answer was generated by AI based on customer and product data.Q: QuestionIs there an accessory included with this grip?
- A:Answer Yes, this grip comes with a free PopChain accessory.
This question and answer was generated by AI based on customer and product data.Q: QuestionCan I swap the top of this grip?
- A:Answer Yes, you can swap the top to change your style.
This question and answer was generated by AI based on customer and product data.Q: QuestionWhat is the product's model number?
- A:Answer The model number for this product is 807742.
This question and answer was generated by AI based on customer and product data.
Page 1, Showing 1-7 of 7 questions
Most-viewed items
- $28.99$28.99The price was $29.99
- $33.99$33.99The price was $34.99
- $7.49$7.49The price was $14.99